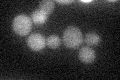
YPL237W
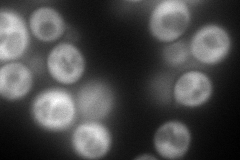
YPL237W
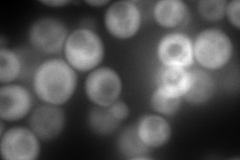
YPL237W
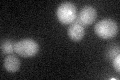
YPL237W

View description
Beta subunit of the translation initiation factor eIF2, involved in the identification of the start codon; proposed to be involved in mRNA binding
Localization:
Intensity:
Fold change:
Significance:
-
C’ GFP library in SD
below threshold17.28 -
N' NOP1pr-GFP in SD
cytosol178.292 -
N' TEF2pr-mCherry in SD
cytosol343.184 -
N' NATIVEpr-GFP in SD

missing0 -
N' TEF2pr-VC and Cyto-VN in SD

#N/A0 -
C’ GFP library in SD+DTT
cytosol18.751.08No -
C’ GFP library in SD+H2O2

cytosol23.031.33No -
C’ GFP library in Starvation Media

cytosol18.711.08No -
C’ GFP library on the background of Pup2-DaMP

below threshold -
C’ GFP library on the background of CCT mutant

below threshold17.6381.02046No
